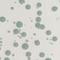
Palm
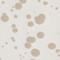
Dune
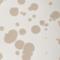
Dune
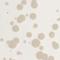
Dune
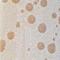
Dune

Inspired by the centuries-old Italian “schizzato” technique, The Splatter Collection celebrates the artful authenticity of the European good life. Use your Splatter Big Plate for any meal of the day, or to serve up fresh fruit and cheese to all your friends after a long, lavish dinner. It’s rimless, coupe-style simplicity makes it an all-purpose crowd pleaser. Available in multiples of four.
Inspired by the centuries-old Italian “schizzato” technique, The Splatter Collection celebrates the artful authenticity of the European good life. Use your Splatter Big Plate for any meal of the day, or to serve up fresh fruit and cheese to all your friends after a long, lavish dinner. It’s rimless, coupe-style simplicity makes it an all-purpose crowd pleaser. Available in multiples of four.
Inspired by the centuries-old Italian “schizzato” technique, The Splatter Collection celebrates the artful authenticity of the European good life. Use your Splatter Big Plate for any meal of the day, or to serve up fresh fruit and cheese to all your friends after a long, lavish dinner. It’s rimless, coupe-style simplicity makes it an all-purpose crowd pleaser. Available in multiples of four.